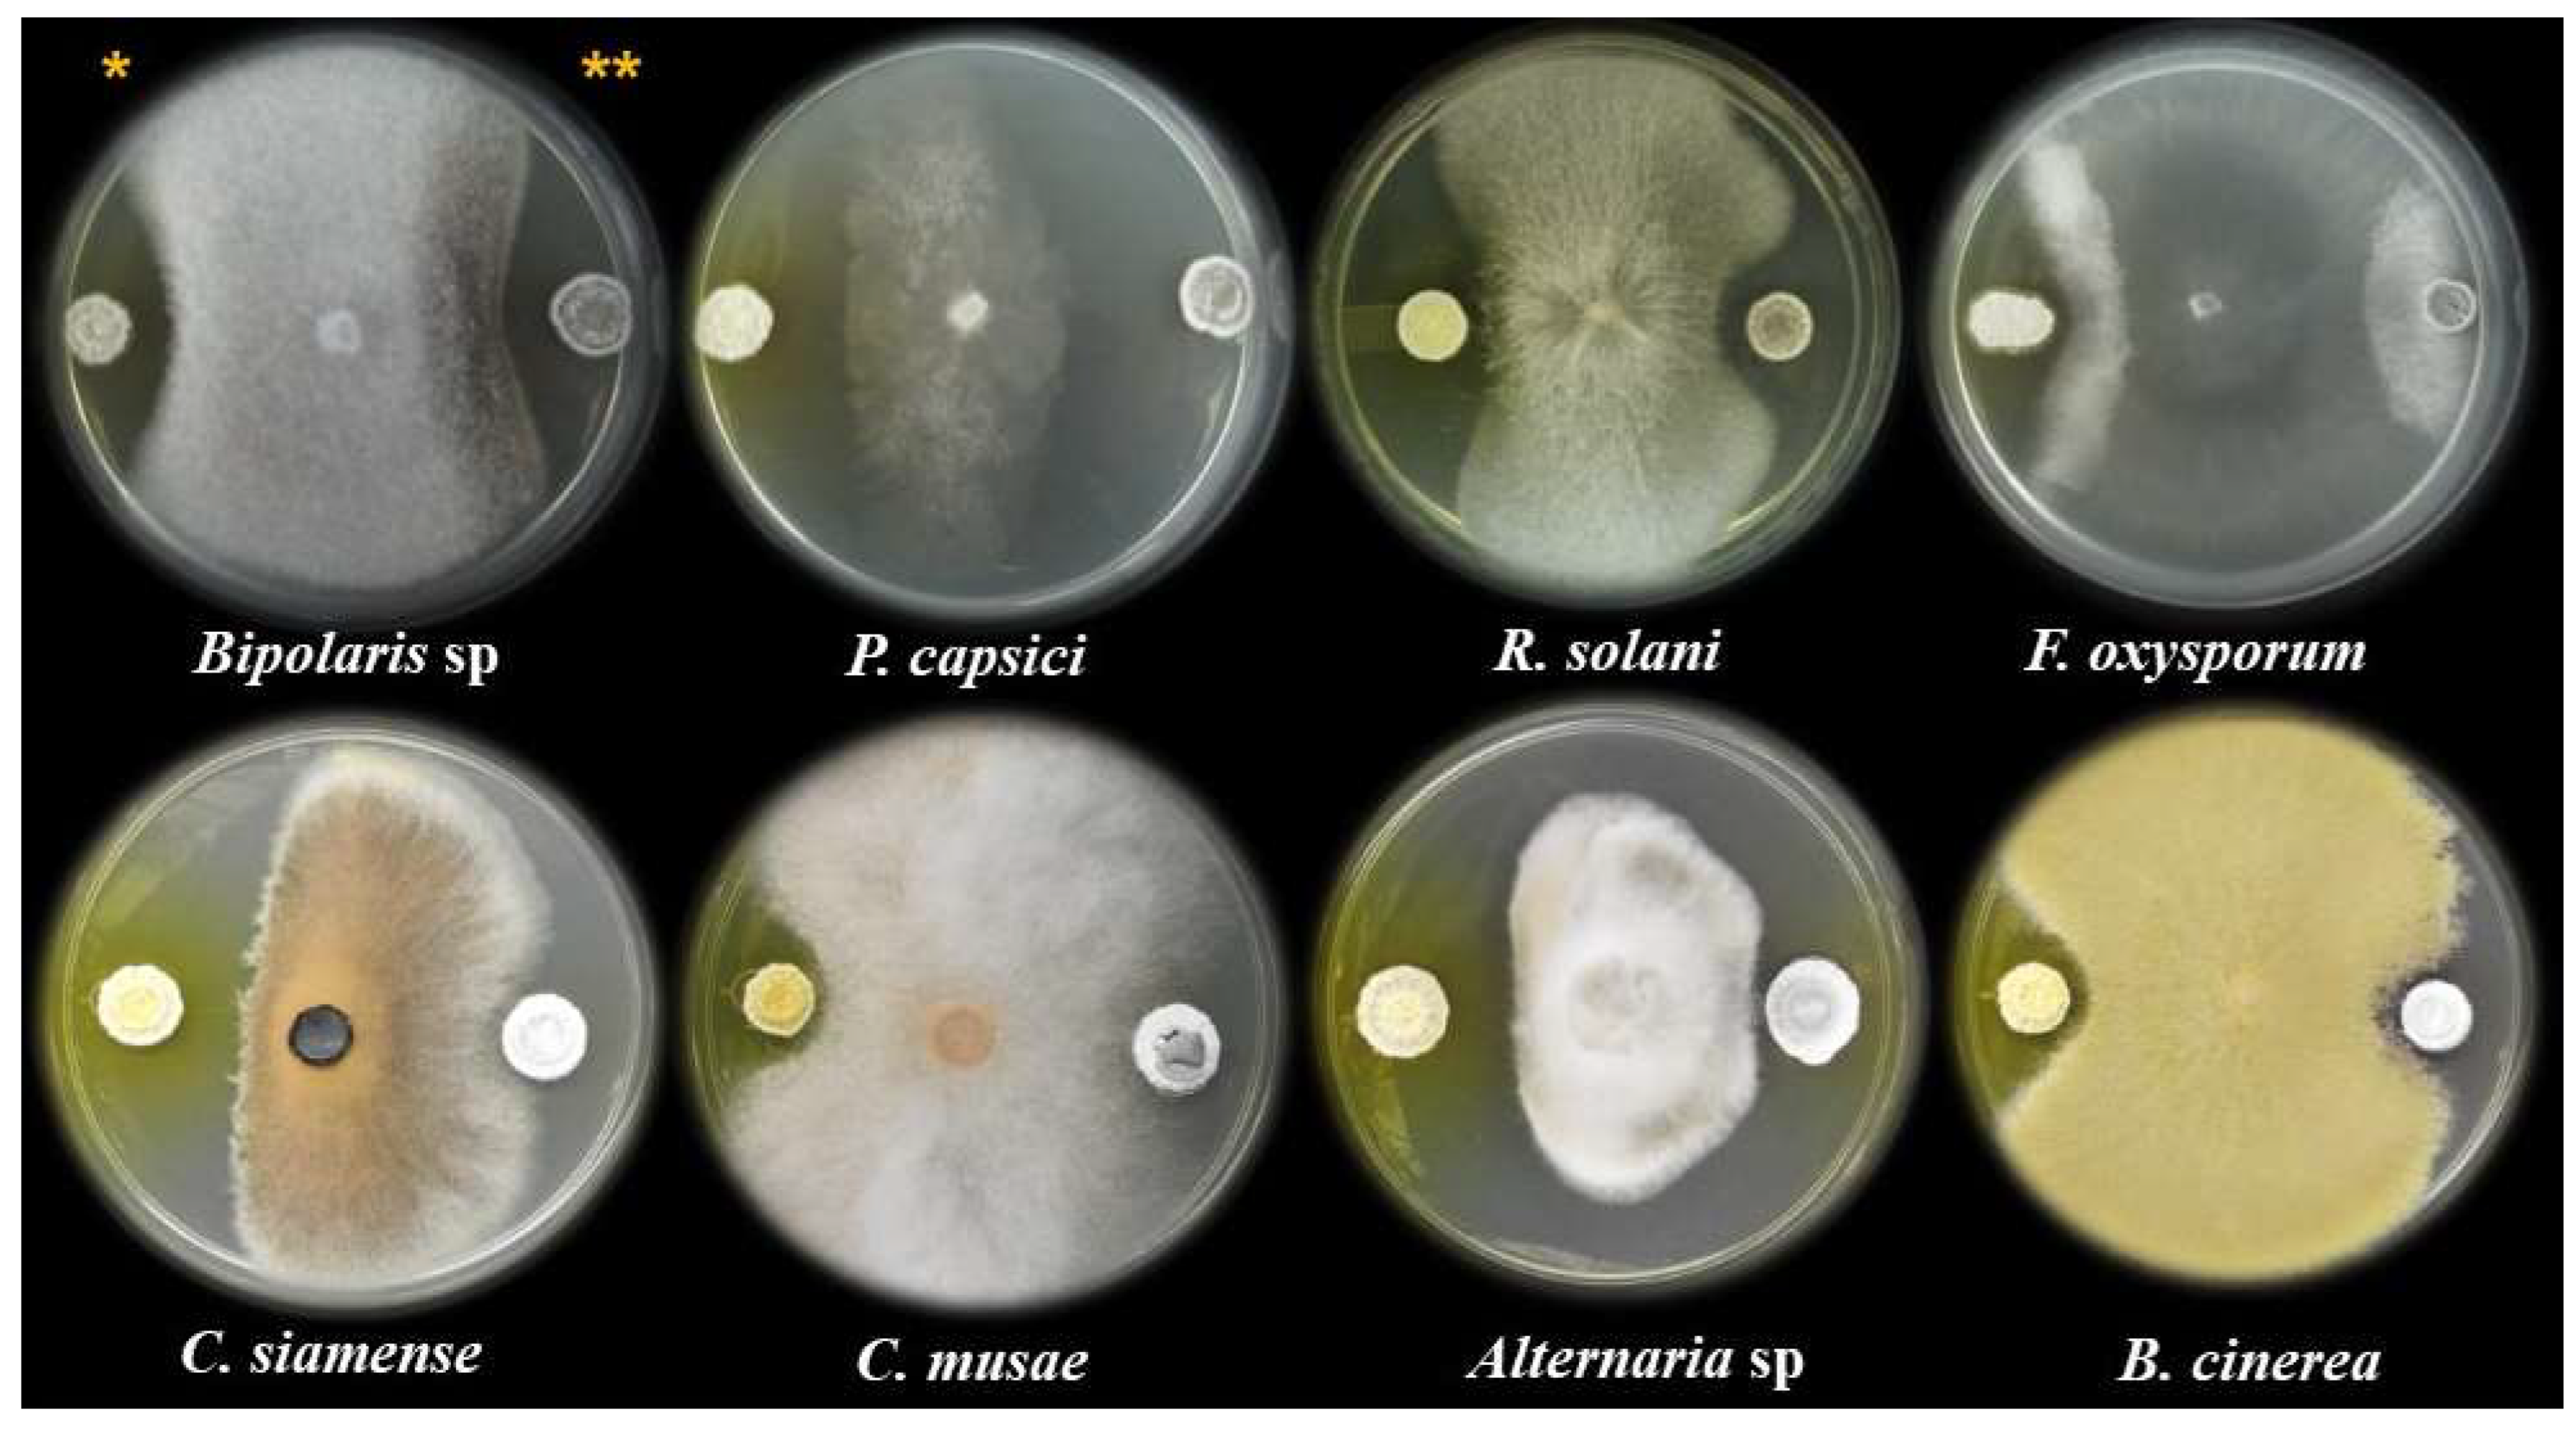
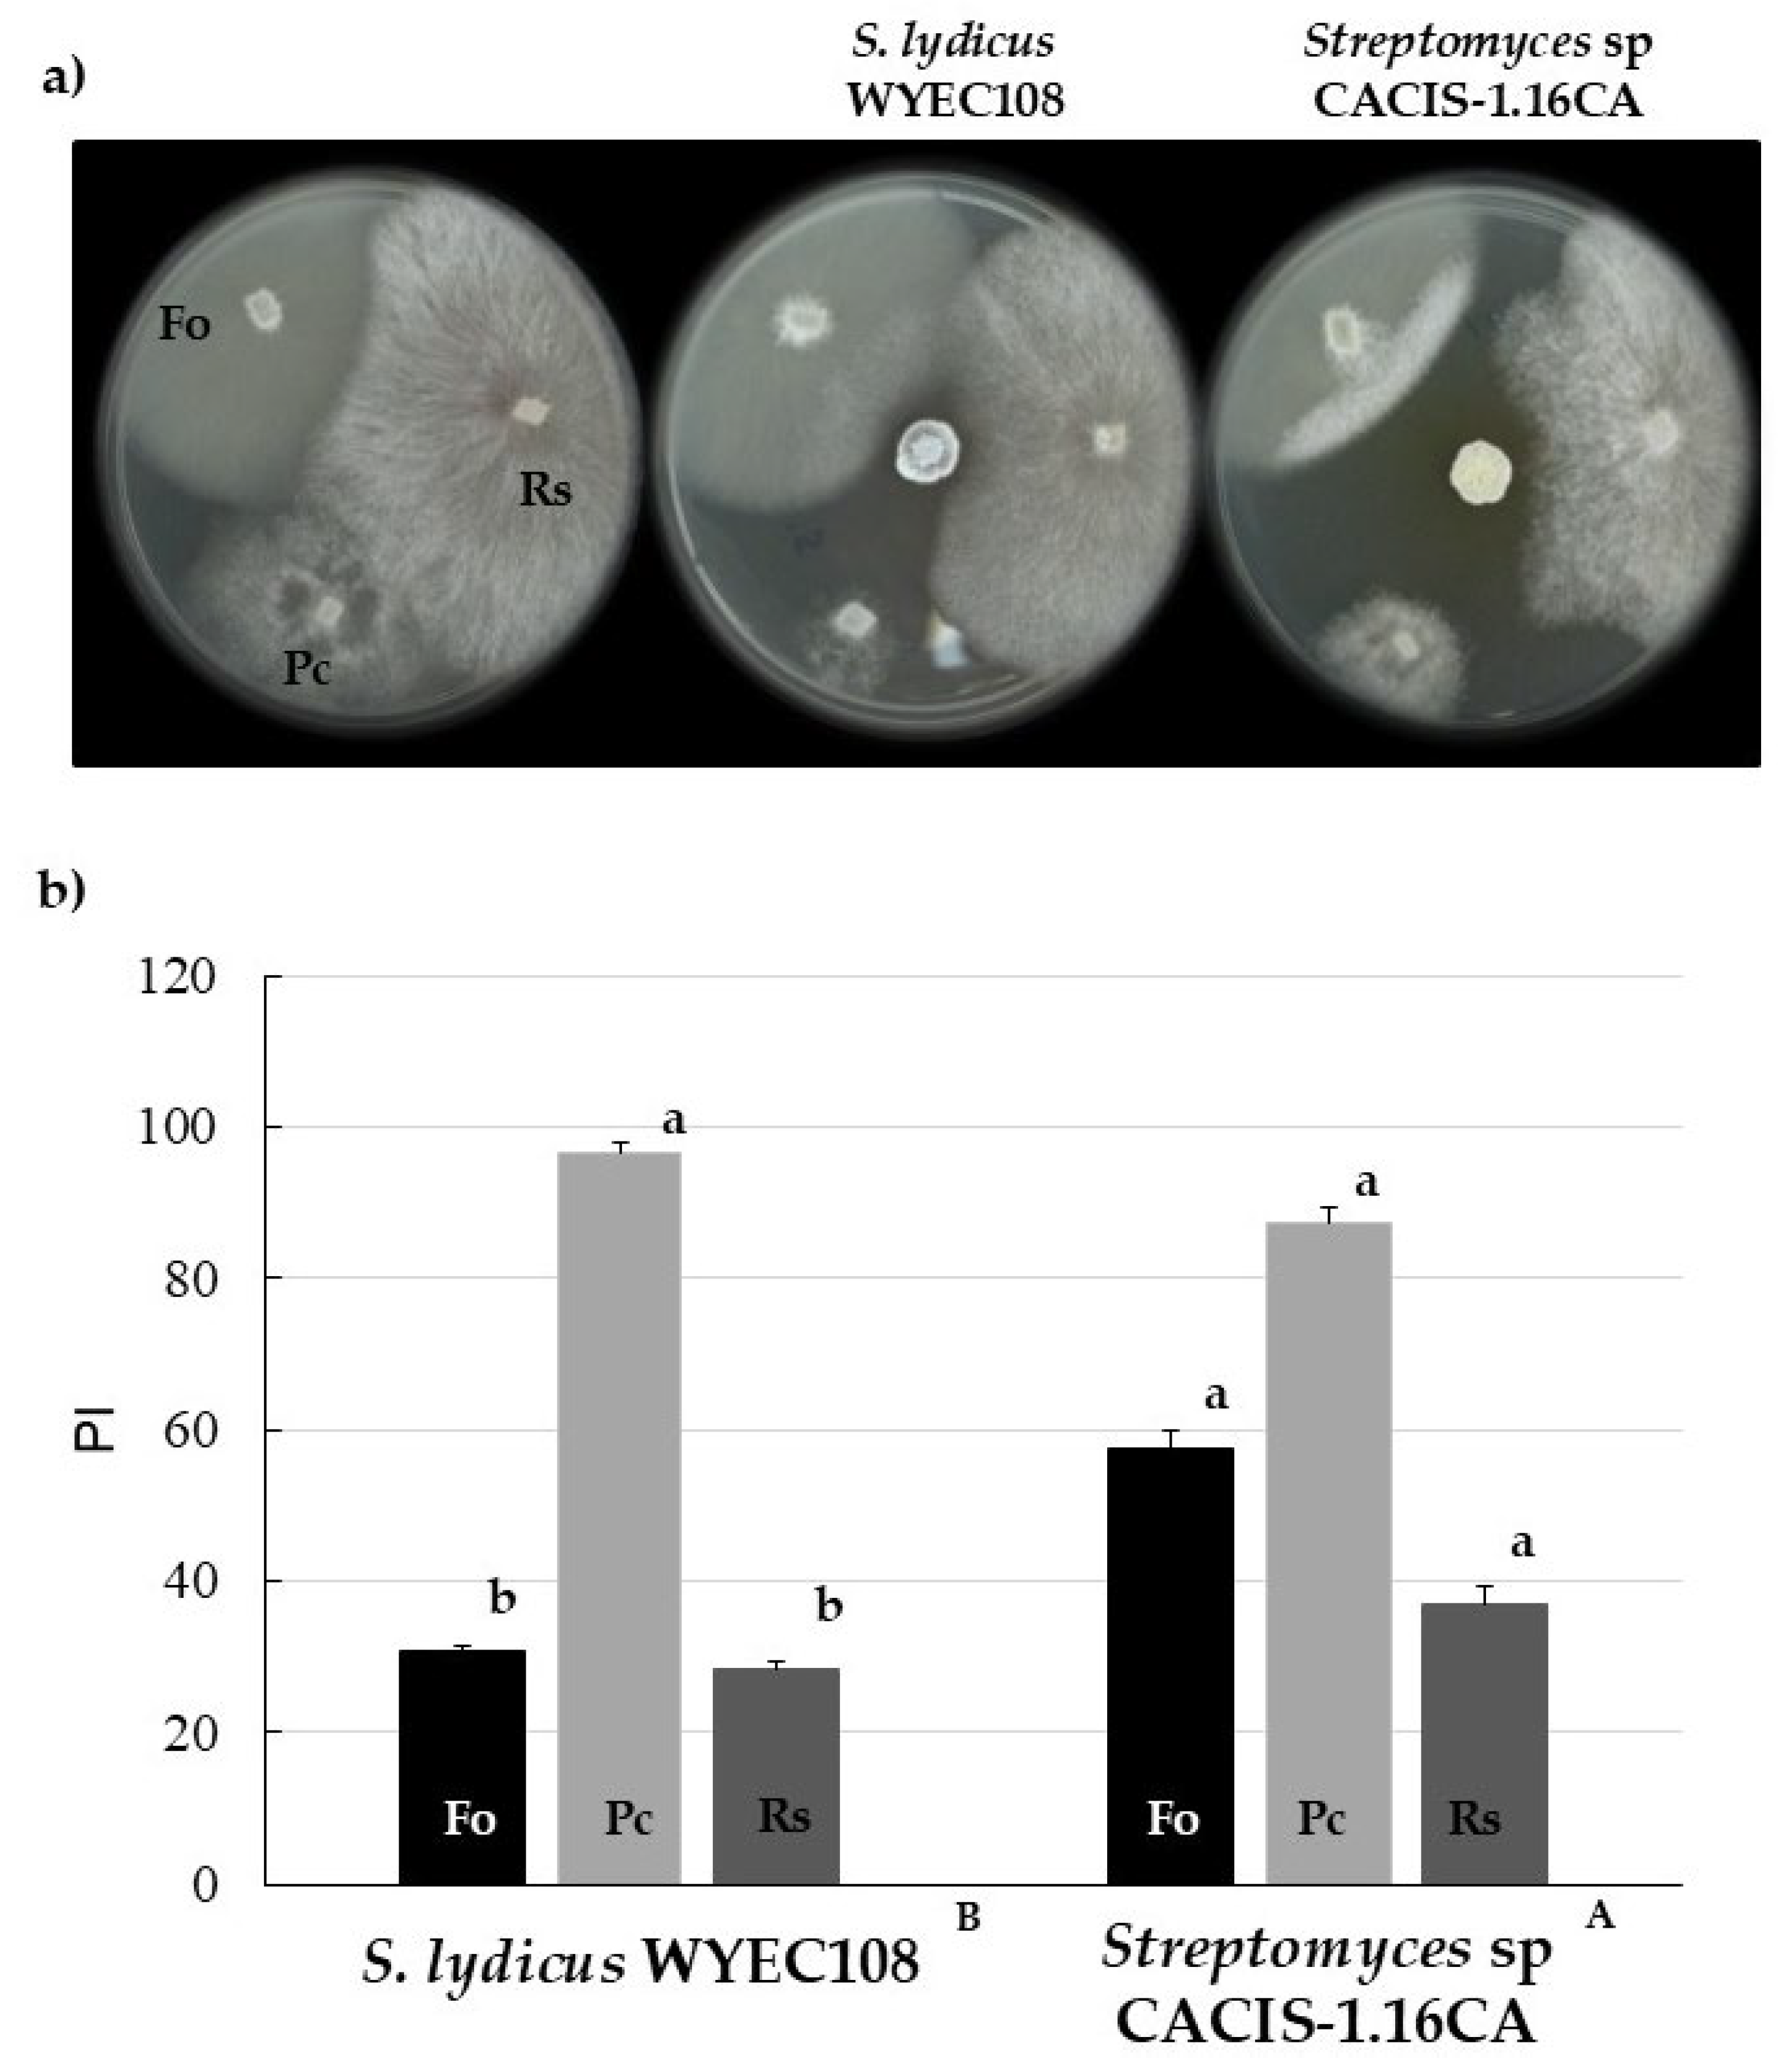

Broad Spectrum Antagonistic Activity of Streptomyces sp. CACIS-1.16CA Against Phytopathogenic Fungi
Abstract
1. Introduction
2. Materials and Methods
2.1. Fungi and Culture Conditions
2.2. Growth Conditions of Streptomyces
2.3. Antagonistic Activity
2.4. Susceptibility Evaluation of Diffusible Secondary Metabolites from Streptomyces sp. CACIS-1.16CA on Fungal Mycelia Growth
2.5. Extraction of Secondary Metabolites and Preparation of the Bioactive Extract (BE)
2.6. Inhibition of Conidial Germination by the BE
2.7. Scanning Electron Microscopy
2.8. Data Analysis
3. Results
3.1. Morphological Characterization of Streptomyces sp. CACIS-1.16CA
3.2. Antagonistic Activity of Streptomyces sp. CACIS-1.16CA
3.3. Antifungal Activity of Diffusible Compounds Produced by Streptomyces sp. CACIS-1.16CA
4. Discussion
5. Conclusions
Author Contributions
Funding
Data Availability Statement
Acknowledgments
Conflicts of Interest
References
- Genilloud, O. Actinomycetes: Still a source of novel antibiotics. Nat. Prod. Rep. 2017, 34, 1203–1232. [Google Scholar] [CrossRef] [PubMed]
- Manteca, Á.; Yagüe, P. Streptomyces as a source of antimicrobials: Novel approaches to activate cryptic secondary metabolite pathways. In Antimicrobials, Antibiotic Resistance, Antibiofilm Strategies and Activity Methods; Kırmusaoğlu, S., Ed.; IntechOpen Limited: London, UK, 2019; pp. 1–21. [Google Scholar] [CrossRef]
- Nithya, K.; Muthukumar, C.; Biswas, B.; Alharbi, N.S.; Kadaikunnan, S. Desert actinobacteria as a source of bioactive compounds production with a special emphasis on pyridine-2,5-diacetamide a new pyridine alkaloid produced by Streptomyces sp. DA3-7. Microbiol. Res. 2018, 207, 116–133. [Google Scholar] [CrossRef]
- Harir, M.; Bendif, H.; Bellahcene, M.; Fortas, Z.; Pogni, R. Streptomyces secondary metabolites. In Basic Biology and Applications of Actinobacteria; Shymaa, E., Ed.; IntechOpen Limited: London, UK, 2018. [Google Scholar] [CrossRef]
- Hasegawa, S.; Meguro, A.; Shimizu, M.; Nishimura, T.; Kunoh, H. Endophytic actinomycetes and their interactions with host plants. Actinomycetologica 2006, 20, 72–81. [Google Scholar] [CrossRef]
- Rodríguez, A.; Acosta, A.; Rodríguez, C. Fungicide resistance of Botrytis cinerea in tomato greenhouses in the Canary Islands and effectiveness of non-chemical treatments against gray mold. World J. Microbiol. Biotechnol. 2014, 30, 2397–2406. [Google Scholar] [CrossRef]
- Sharma, N.; Sharma, S. Control of foliar diseases of mustard by Bacillus from reclaimed soil. Microbiol. Res. 2008, 163, 408–411. [Google Scholar] [CrossRef] [PubMed]
- Heydaria, A.; Pessarakli, M. A review on biological control of fungal plant pathogens using microbial antagonists. J. Biol. Sci. 2010, 10, 273–290. [Google Scholar] [CrossRef]
- Faheem, M.; Raza, W.; Zhong, W.; Nan, Z.; Shen, Q.; Xu, Y. Evaluation of the biocontrol potential of Streptomyces goshikiensis YCXU against Fusarium oxysporum f. sp. niveum. Biol. Control 2015, 81, 101–110. [Google Scholar] [CrossRef]
- Lahdenperä, M.L.; Simon, E.; Uoti, J. Mycostop—A novel biofungicide based on Streptomyces bacteria. Dev. Agric. Manag. Forest Ecol. 1991, 23, 258–263. [Google Scholar] [CrossRef]
- Crawford, D.L.; Lynch, J.M.; Whipps, J.M.; Ousley, M.A. Isolation and characterization of actinomycete antagonist of a fungal root pathogen. Appl. Environ. Microbiol. 1993, 59, 3899–3905. [Google Scholar] [CrossRef]
- Manhas, R.K.; Kaur, T. Biocontrol potential of Streptomyces hydrogenans strain DH16 toward Alternaria brassicicola to control damping off and black leaf spot of Raphanus sativus. Front. Plant Sci. 2016, 7, 1869. [Google Scholar] [CrossRef] [PubMed]
- Singh, S.P.; Gaur, R. Evaluation of antagonistic and plant growth promoting activities of chitinolytic endophytic actinomycetes associated with medicinal plants against Sclerotium rolfsii in chickpea. J. Appl. Microbiol. 2016, 121, 506–518. [Google Scholar] [CrossRef]
- Yang, Y.; Zhang, S.W.; Li, K.T. Antagonistic activity and mechanism of an isolated Streptomyces corchorusii stain AUH-1 against phytopathogenic fungi. World J. Microbiol. Biotechnol. 2019, 35, 145. [Google Scholar] [CrossRef]
- Rios-Muñiz, D.E.; Evangelista-Martínez, Z. Antifungal activity of Streptomyces sp. CACIS-2.15CA, as a potential biocontrol agent, against some soil-borne fungi. Egypt. J. Biol. Pest Control 2022, 32, 130. [Google Scholar] [CrossRef]
- Evangelista-Martínez, Z. Isolation and characterization of soil Streptomyces species as a potential biological control agent against fungal plant pathogens. World J. Microbiol. Biotechnol. 2014, 30, 1639–1647. [Google Scholar] [CrossRef] [PubMed]
- Evangelista-Martínez, Z. Inhibitory activity of thermo-resistant metabolites produced by Streptomyces sp. CACIS-1.16CA against human and plant pathogenic bacteria. J. Microbiol. Biotech. Food Sci. 2022, 12, e3329. [Google Scholar] [CrossRef]
- Evangelista-Martínez, Z.; Contreras-Leal, E.A.; Corona-Pedraza, L.F.; Gastélum-Martínez, E. Biocontrol potential of Streptomyces sp. CACIS-1.5CA against phytopathogenic fungi causing postharvest fruit diseases. Egypt. J. Biol. Pest Control 2020, 30, 117. [Google Scholar] [CrossRef]
- Oliveira, D.G.P.; Pauli, G.; Mascarin, G.M.; Delalibera, I. A protocol for determination of conidial viability of the fungal entomopathogens Beauveria bassiana and Metarhizium anisopliae from commercial products. J. Microbiol. Methods 2015, 119, 44–52. [Google Scholar] [CrossRef] [PubMed]
- Shirling, E.B.; Gottlieb, D. Methods for characterization of Streptomyces species. Int. J. Syst. Bacteriol. 1966, 16, 313–340. [Google Scholar] [CrossRef]
- Anith, K.N.; Nysanth, N.S.; Natarajan, C. Novel and rapid agar plate methods for in vitro assessment of bacterial biocontrol isolates’ antagonism against multiple fungal phytopathogens. Lett. Appl. Microbiol. 2021, 73, 229–236. [Google Scholar] [CrossRef]
- Singh, L.S.; Sharma, H.; Talukdar, N.C. Production of potent antimicrobial agent by actinomycete, Streptomyces sannanensis strain SU118 isolated from phoomdi in Loktak Lake of Manipur, India. BMC Microbiol. 2014, 14, 278. [Google Scholar] [CrossRef]
- Córdova-Dávalos, L.E.; Escobedo-Chávez, K.G.; Evangelista-Martínez, Z. Inhibition of Candida albicans cell growth and biofilm formation by a bioactive extract produced by soil Streptomyces strain GCAL-25. Arch. Biol. Sci. 2018, 70, 387–396. [Google Scholar] [CrossRef]
- Lee, J.-E.; Jayakody, J.T.M.; Kim, J.-I.; Jeong, J.-W.; Choi, K.-M.; Kim, T.-S.; Seo, C.; Azimi, I.; Hyun, J.; Ryu, B. The influence of solvent choice on the extraction of bioactive compounds from Asteraceae: A comparative review. Foods 2024, 13, 3151. [Google Scholar] [CrossRef]
- Zhang, X.; Wang, H.; Zhu, W.; Li, W.; Wang, F. Transcriptome analysis reveals the effects of chinese Chive (Allium tuberosum R.) extract on Fusarium oxysporum f. sp. radicis-lycopersici spore germination. Curr. Microbiol. 2020, 77, 855–864. [Google Scholar] [CrossRef]
- Li, Q.; Chen, X.; Jiang, Y.; Jiang, C. Morphological identification of actinobacteria. In Actinobacteria—Basics and Biotechnological Applications; Dhanasekaran, D., Jiang, Y., Eds.; IntTechoOpen Limited: London, UK, 2016; pp. 59–86. [Google Scholar] [CrossRef]
- Davidsson, P.R.; Kariola, T.; Niemi, O.; Palva, E.T. Pathogenicity of and plant immunity to soft rot pectobacteria. Front. Plant Sci. 2013, 4, 191. [Google Scholar] [CrossRef] [PubMed]
- Hernández-Castillo, F.D.; Lira, S.R.H.; Gallegos, M.G.; Hernández, S.M.; Solis, G.S. Biocontrol of pepper wilt with three Bacillus species and its effect on growth and yield. Phyton 2014, 83, 49–55. [Google Scholar] [CrossRef]
- Vallejo-Gutiérrez, A.J.; Mejía-Carranza, J.; García-Velasco, R.; Ramírez-Gerardo, M.G. Response of Capsicum pubescens genotypes to damage caused by the fungal wilt complex. Mex. J. Phytopathol. 2019, 37, 50–70. [Google Scholar] [CrossRef]
- Lamichhane, J.R.; Dürr, C.; Schwanck, A.A.; Robin, M.H.; Sarthou, J.P.; Cellier, V.; Messéan, A.; Aubertot, J.N. Integrated management of damping-off diseases. A review. Agron. Sustain. Dev. 2017, 37, 10. [Google Scholar] [CrossRef]
- Prapagdee, B.; Kuekulvong, C.; Mongkolsuk, S. Antifungal potential of extracellular metabolites produced by Streptomyces hygroscopicus against phytopathogenic fungi. Int. J. Biol. Sci. 2008, 4, 330–337. [Google Scholar] [CrossRef]
- Shahid, M.; Singh, B.N.; Verma, S.; Choudhary, P.; Das, S.; Chakdar, H.; Murugan, K.; Goswami, S.K.; Saxena, A.K. Bioactive antifungal metabolites produced by Streptomyces amritsarensis V31 help to control diverse phytopathogenic fungi. Braz. J. Microbiol. 2021, 52, 1687–1699. [Google Scholar] [CrossRef]
- Chen, Y.; Zhou, D.; Qi, D.; Gao, Z.; Xie, J.; Luo, Y. Growth promotion and disease suppression ability of a Streptomyces sp. CB-75 from banana rhizosphere soil. Front. Microbiol. 2018, 8, 2704. [Google Scholar] [CrossRef]
- Kim, Y.J.; Kim, J.H.; Rho, J.Y. Antifungal activities of Streptomyces blastmyceticus strain 12-6 against plant pathogenic fungi. Mycobiology 2019, 47, 329–334. [Google Scholar] [CrossRef] [PubMed]
- Lu, X.; Zhou, J.; Ming, Y.; Wang, Y.; He, R.; Li, Y.; Feng, L.; Zeng, B.; Du, Y.; Wang, C. Next-generation antifungal drugs: Mechanisms, efficacy, and clinical prospects. Acta Pharm. Sin. B 2025, 15, 3852–3887. [Google Scholar] [CrossRef]

| Fungi | Hosts | Streptomyces sp. CACIS-1.16CA A | S. lydicus WYEC 108 B |
|---|---|---|---|
| Bipolaris sp. | Habanero pepper | 43.3 ± 1.7 a | 42.2 ± 1.2 a |
| Phomopsis sp. | Jatropha curcas | 57.6 ± 2.6 a | 38.0 ± 0.7 b |
| Corynespora casiicolla | Jatropha curcas | 60.2 ± 0.9 a | 53.2 ± 0.4 b |
| Fusarium equisetti | Habanero pepper | 51.5 ± 3.0 a | 37.6 ± 1.6 b |
| F. oxysporum f. sp. lycopersici | Tomato | 44.6 ± 2.5 a | 5.9 ± 1.7 b |
| Fusarium sp. CDBB 1172 1 | CDBB | 52.9 ± 1.5 a | 36.1 ± 1.5 b |
| Fusarium solani | Potato | 46.8 ± 0.1 a | 35.9 ± 0.7 b |
| Fusarium oxysporum | Agave | 47.3 ± 1.1 a | 1.9 ± 0.6 b |
| Phytophthora capsici | Serrano pepper | 60.2 ± 3.6 b | 68.5 ± 2.2 a |
| Rhizoctonia solani | Serrano pepper | 46.8 ± 2.8 a | 46.7 ± 0.8 a |
| Sclerotium sp. | Aloe | 47.5 ± 2.8 a | 34.8 ± 4.9 b |
| Colletotrichum siamense M1.2 | Habanero pepper | 72.0 ± 2.9 a | 34.7 ± 2.8 b |
| Colletotrichum musae Cm6 | Banana fruit | 47.5 ± 1.7 a | 41.4 ± 4.8 b |
| Alternaria sp. | Tomato | 64.9 ± 5.6 a | 49.9 ± 5.1 b |
| Aspergillus sp. | Sweet citrus | 49.3 ± 2.4 a | 4.7 ± 1.4 b |
| Botrytis cinerea | Tomato | 44.4 ± 5.6 a | 45.5 ± 1.9 a |
Disclaimer/Publisher’s Note: The statements, opinions and data contained in all publications are solely those of the individual author(s) and contributor(s) and not of MDPI and/or the editor(s). MDPI and/or the editor(s) disclaim responsibility for any injury to people or property resulting from any ideas, methods, instructions or products referred to in the content. |
© 2025 by the authors. Licensee MDPI, Basel, Switzerland. This article is an open access article distributed under the terms and conditions of the Creative Commons Attribution (CC BY) license (https://creativecommons.org/licenses/by/4.0/).
Share and Cite
Vargas-Gómez, K.A.; Evangelista-Martínez, Z.; Gastélum-Martínez, É.; Uc-Varguez, A.; Quiñones-Aguilar, E.E.; Rincón-Enríquez, G. Broad Spectrum Antagonistic Activity of Streptomyces sp. CACIS-1.16CA Against Phytopathogenic Fungi. Microbiol. Res. 2025, 16, 193. https://doi.org/10.3390/microbiolres16090193
Vargas-Gómez KA, Evangelista-Martínez Z, Gastélum-Martínez É, Uc-Varguez A, Quiñones-Aguilar EE, Rincón-Enríquez G. Broad Spectrum Antagonistic Activity of Streptomyces sp. CACIS-1.16CA Against Phytopathogenic Fungi. Microbiology Research. 2025; 16(9):193. https://doi.org/10.3390/microbiolres16090193
Chicago/Turabian StyleVargas-Gómez, Karen A., Zahaed Evangelista-Martínez, Élida Gastélum-Martínez, Alberto Uc-Varguez, Evangelina E. Quiñones-Aguilar, and Gabriel Rincón-Enríquez. 2025. "Broad Spectrum Antagonistic Activity of Streptomyces sp. CACIS-1.16CA Against Phytopathogenic Fungi" Microbiology Research 16, no. 9: 193. https://doi.org/10.3390/microbiolres16090193
APA StyleVargas-Gómez, K. A., Evangelista-Martínez, Z., Gastélum-Martínez, É., Uc-Varguez, A., Quiñones-Aguilar, E. E., & Rincón-Enríquez, G. (2025). Broad Spectrum Antagonistic Activity of Streptomyces sp. CACIS-1.16CA Against Phytopathogenic Fungi. Microbiology Research, 16(9), 193. https://doi.org/10.3390/microbiolres16090193

